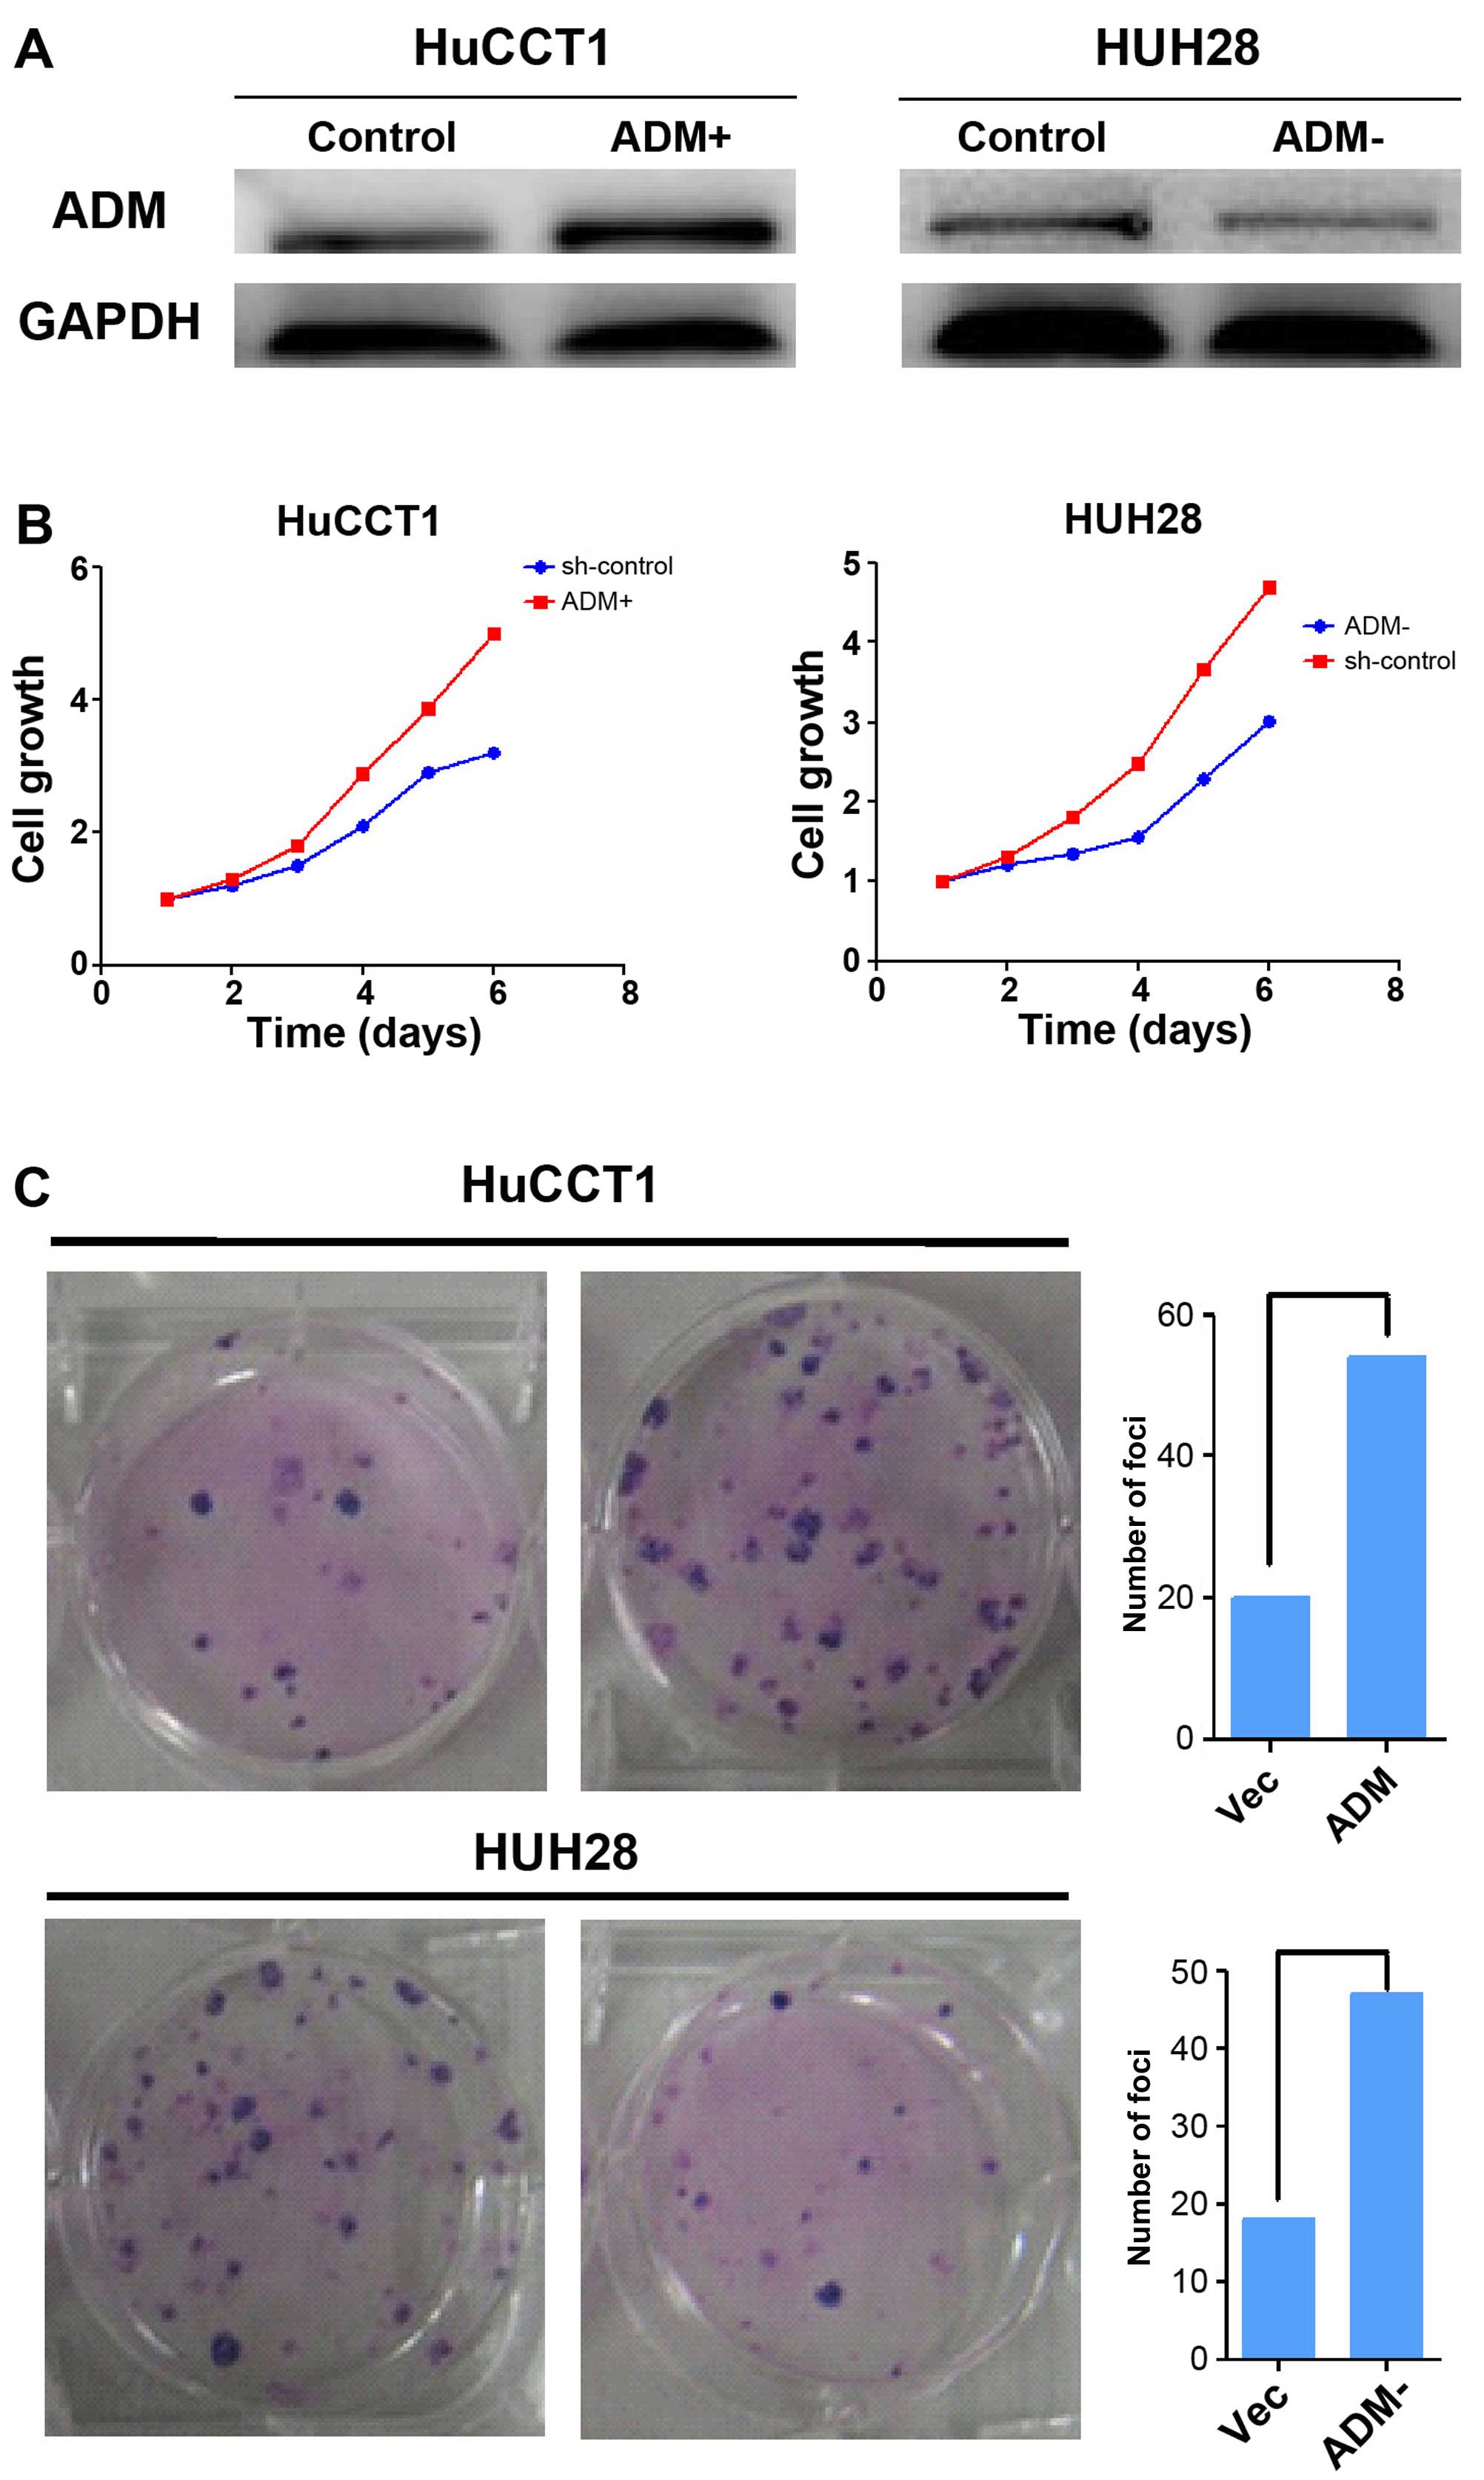

Introduction
Intrahepatic cholangiocarcinoma (ICC) is defined as
a chol-angiocarcinoma located proximally to the second-degree bile
ducts. It is an aggressive neoplasm associated with extremely poor
survival. The incidence and mortality of ICC have increased
worldwide over the past two decades (1–3).
Surgical treatment is the only curative treatment option for ICC,
and the 5-year survival rate for patients with unresectable ICC is
currently <5% (4), compared with
20–44% in patients undergoing resection at early T1–T2 stages.
Tumor recurrence and metastasis are common in ICC (5), and the prevention of recurrence is
thus the key to improving patient overall survival (OS).
Adrenomedullin (ADM) is a multifunctional regulatory and vasoactive
peptide originally isolated from human pheo-chromocytoma (6). ADM overexpression has been detected in
human breast, lung, ovarian, pancreatic, prostate and renal cancers
(7–9). However, the physiologic significance
of ADM in ICC metastasis and its underlying molecular mechanism are
largely unknown. A better understanding of the biological
characteristics of ICC that contribute to tumor invasion and
metastasis is paramount for developing novel strategies to treat
this cancer.
Materials and methods
Clinical samples and cell lines
This study included 80 men and 53 women with an
average age of 55.6±12.8 years (range, 27–84 years), who had
undergone curative resection at the First Affiliated Hospital of
Zhengzhou University (Zhengzhou, Henan, China) from January 2005 to
December 2008. The diagnosis of ICC was confirmed by morphological
criteria, immunohistochemical (IHC) staining and clinical findings.
None of the patients had received any preoperative anticancer
treatment. The present study was approved by the Human Ethics
Committee of the First Affiliated Hospital of Zhengzhou University,
and informed consent was obtained from all patients according to
the committee’s regulations and the Declaration of Helsinki. The
clinical characteristics of the patients with ICC are presented in
Table I. Functional studies were
performed using HuCCT1 and HUH28 cholangiocarci-noma cell lines
(Shanghai Institutes for Biological Sciences, Chinese Academy of
Sciences, Shanghai, China). The cell lines were cultured in
RPMI-1640 medium supplemented with 10% fetal bovine serum (FBS),
100 U/ml penicillin, 0.1 mg/ml streptomycin and 2 mmol/l
L-glutamine.
 | Table IClinicopathological characteristics of
the 133 patients with ICC. |
Table I
Clinicopathological characteristics of
the 133 patients with ICC.
| Demographics | Recurrence group
A
(n=54) | Non-recurrence group
B
(n=79) | P-valueb |
|---|
| Gender | | | |
| Male | 28 | 52 | 0.10606 |
| Female | 26 | 27 | |
| Age (years) | | | |
| >60 | 27 | 31 | 0.21914 |
| ≤60 | 27 | 48 | |
|
Differentiationa | | | |
| I–II | 33 | 53 | 0.47882 |
| III–IV | 21 | 26 | |
| Encapsulation | | | |
| Complete | 4 | 10 | 0.33254 |
| None | 50 | 69 | |
| CA19–9 (U/ml) | | | |
| ≤37 | 28 | 38 | 0.01929 |
| >37 | 42 | 25 | |
| Lymph node
metastasis | | | |
| Presence | 11 | 13 | 0.77174 |
| Absence | 49 | 66 | |
| Tumor size (cm) | | | |
| ≤5 | 21 | 42 | 0.10539 |
| >5 | 33 | 37 | |
| ADM | | | |
| Low ≤6 | 23 | 50 | 0.01848 |
| High | 31 | 29 | |
Total RNA extraction, cDNA synthesis, RNA
isolation and real-time polymerase chain reaction (RT-PCR)
Total RNA was extracted from ICC and liver tissues
using TRIzol reagent (Invitrogen, Carlsbad, CA, USA). The quality
and concentration of the isolated RNA were measured with a NanoDrop
ND-1000 spectrophotometer (NanoDrop Technologies, Montchanin, DE,
USA). First-strand cDNA was synthesized using both oligo-dT primers
and random 6-mers and PrimeScript RT Enzyme Mix I according to the
manufacturer’s instructions (Takara, Otsu, Shiga, Japan).
RT-PCR was performed using specific TaqMan probes
and primer sets to examine ADM RNA expression levels.
TATA-box-binding protein (TBP), which is considered to be a
reliable reference gene for quantitative PCR normalization in HCC
specimens, was used as a control (10). Commercialized probes and primer sets
specific for ADM and TBP were purchased from Applied Biosystems
(Foster City, CA, USA). TaqMan primers and probes for ADM and TBP
were designed using Primer Express (Applied Biosystems). The
transcripts were amplified with the TaqMan One-Step RT-PCR Master
Mix reagent and ABI Prism 7900HT sequence detection system (both
from Applied Biosystems). The expression levels of the tested genes
were quantified in relation to the expression of TBP using sequence
detector software and the relative quantification method (Applied
Biosystems). The relative ADM mRNA levels were determined using the
2−ΔΔCT method (11).
Tissue microarray (TMA) and IHC
A tissue microarray was constructed as described
previously (12). Samples were
taken from each representative tumor tissue and from liver tissue
adjacent to the tumor (within 10 mm) to construct TMA slides (in
collaboration with the Shanghai Biochip Company Ltd., Shanghai,
China). Duplicate tissue cylinders were obtained from intratumoral
and peritumoral areas (a total of 4 punches for each patient).
Tissues were incubated with primary rabbit anti-ADM monoclonal
antibody (1:200; Abcam, Cambridge, MA, USA), according to
previously described IHC protocols (13), using the EnVision Plus detection
system (EnVision; Dako, Carpinteria, CA, USA). Reaction products
were visualized by incubation with 3,3-diaminobenzidine.
Semi-quantitative analysis of IHC staining was performed by two
experienced pathologists in two sections of each specimen in 10
fields from each section (magnification, ×200). Immunostaining
scoring was based on the intensity of staining and the percentage
of positively stained cells: negative (−), 0–5%; intermediate (+),
>5–10%; moderate (++), >10–25%; strong (+++), >25%. ADM
staining ≥5% was considered positive.
Construction of recombinant plasmids and
transfection
Full-length human ADM cDNA was amplified by PCR and
cloned into the pEGFP-N1 expression vector (Clontech, Palo Alto,
CA, USA) to construct pEGFP-N1-ADM, and then transfected into
HuCCT1 cells using Lipofectamine 2000 (Invitrogen) according to the
manufacturer’s instructions. Cells transfected with pEGFP-N1 were
used as a negative control. Stable ADM-expressing clones were
selected using geneticin (Roche Diagnostics, Indianapolis, IN, USA)
at a concentration of 500 µg/ml.
Establishment of ADM-knockdown cells
Lentivirus containing short hairpin RNAs targeting
ADM was purchased from GeneCopoeia (Rockville, MD, USA) and
transfected into HUH28 cells using Lipofectamine 2000 (Invitrogen)
according to the manufacturer’s instructions. Cells transfected
with the empty vector were used as controls. Stable clones were
selected using puromycin (final concentration, 2 µg/ml).
In vitro cell behavior assay
Cellular proliferation was assayed in cells seeded
at a density of 5×103 cells/well in 96-well plates. The
proliferation of the transfected cells was measured using a CyQUANT
Cell Proliferation Assay kit (Invitrogen). Each assay was repeated
3 times. For wound-healing assays, monolayers of cells were wounded
by scraping with a plastic pipette tip followed by rinsing several
times with medium to remove dislodged cells. Cells that had
migrated into the wound area were photographed. For invasion
assays, 2×105 cells were plated into the upper chamber
of a polycarbonate Transwell filter chamber coated with Matrigel
(BD Pharmingen, San Diego, CA, USA) and incubated for 48 h. The
cells that migrated to the underside of the membrane were stained
with Giemsa (Sigma-Aldrich, St. Louis, MO, USA) and counted under a
microscope (Olympus, Japan).
Statistical analysis
Survival was analyzed using the Kaplan-Meier
estimate, and values were compared using the log-rank test.
Independent prognostic factors were identified by multivariate
survival analysis using a Cox proportional hazards model. The
median value was used to determine the cut-off value for high vs.
low expression of ADM. Statistical analyses were performed with
SPSS 16.0 for Windows (SPSS software; SPSS Inc., Chicago, IL, USA).
Statistical significance was accepted for P<0.05 for all
tests.
Results
Expression of ADM in human ICC
The significance of ADM expression in ICC patients
was investigated by IHC (Fig. 1).
ADM staining was mainly located in the cytoplasm of tumor cells.
Most stromal cells were negative for ADM. As shown in Fig. 2, ADM mRNA expression was
significantly higher in the ICC tumor tissues compared with that in
the peritumoral and healthy liver tissues, according to RT-PCR.
We investigated the clinical significance of ADM
overex-pression in ICC by tissue microarray analysis of ICC tissues
from 133 patients who underwent resection (Table I). Kaplan-Meier analysis revealed
that patients with high ADM expression had poorer OS and shorter
time to recurrence (TTR) (both P<0.01, Fig. 3). Univariate Cox regression analysis
identified differentiation, encapsulation and ADM overexpression as
factors significantly associated with OS, while multivariate Cox
proportional hazards regression analysis identified differentiation
and ADM overexpression as independent prognostic factors for OS in
ICC patients (Table II).
 | Table IIUnivariate and multivariate analyses
of factors associated with survival and recurrence. |
Table II
Univariate and multivariate analyses
of factors associated with survival and recurrence.
| Factor | Univariate
| Multivariate
|
|---|
| Hazard ratio (95%
CI) |
P-valuea | Hazard ratio (95%
CI) |
P-valuea |
|---|
| Gender (female vs.
male) | 0.782
(0.430–1.423) | 0.421 | | |
| Age (>60 vs. ≤60
years) | 0.899
(0.472–1.713) | 0.746 | | |
| Tumor size (>5 vs.
≤5 cm) | 0.902
(0.493–1.650) | 0.738 | | |
| Differentiation
(I–II vs. III–IV) | 2.581
(1.216–5.481) | 0.014 | 2.177
(1.016–4.665) | 0.045 |
| CA19–9 (>37 vs.
≤37 U/ml) | 0.779
(0.409–1.480) | 0.445 | | |
| Encapsulation
(complete vs. none) | 2.609
(0.921–7.338) | 0.041 | 1.497
(0.503–4.456) | 0.469 |
| ADM (positive vs.
negative) | 2.869
(1.453–5.665) | 0.002 | 2.412
(1.207–4.823) | 0.013 |
Effect of ADM on ICC cell growth
To confirm the involvement of ADM in the growth of
ICC cells, we transfected HuCCT1 cells with ADM and silenced HUH28
cells with short hairpin RNA, respectively. ADM expression was
determined by western blotting (Fig.
4A). The tumorigenicity of ADM was determined by functional
assays. The cell growth rates in the ADM-transfected cells were
significantly higher than the rates in the control cells
(P<0.01, Fig. 4B).
ADM-transfected cells also formed significantly more and larger
colonies (P<0.01) than the control cells (Fig. 4C).
Effects of ADM on ICC cell migration and
tumor metastasis
The roles of ADM in tumor cell migration and
invasion were investigated by wound-healing and Transwell invasion
assays. ADM-transfected cells achieved faster closure of the
scratched ̔wounds’ than this rate in the control cells (Fig. 5A). Furthermore, cell motility and
invasion in the Transwell invasion assays were significantly
increased by ADM transfection (P<0.05, Fig. 5B). Opposite results were obtained in
the ADM-silenced cells.
Effect of ADM on epithelial-mesenchymal
transition (EMT) in ICC
EMT is one of the key events in tumor invasion and
metastasis. We therefore investigated the effects of ADM on EMT by
analyzing the expression levels of EMT markers and EMT-related
transcription factors, and by morphological changes in the ICC cell
lines. Western blotting demonstrated decreased expression levels of
the epithelial markers E-cadherin and ZO-1, and increased
expression of the mesenchymal markers vimentin and N-cadherin, and
the EMT-related transcription factors ZEB1 and ZEB2 in the
ADM-transfected cells (Fig. 6),
compared with the control cells. Opposite expression patterns of
these genes were observed in the ADM-silenced cells.
Discussion
ADM expression has been demonstrated in many human
malignant cells (14,15), but to the best of our knowledge, the
present study is the first to report ADM expression and its
specific mechanisms in ICC. ADM protein was highly expressed in
ICCs according to IHC, while ADM mRNA expression levels were higher
in the tumor tissues compared with that in the peritumoral and
healthy tissues. Overexpression of ADM was significantly associated
with poorer OS (P<0.001) and tumor recurrence (P<0.01). These
results suggest that ADM acts as an oncogene with an important role
in ICC progression.
EMT is considered to be a critical mechanism
involved in cancer metastasis (16,17);
however, compared with other types of human cancers, few studies
have focused on the significance of EMT in ICC (18,19).
Our functional studies demonstrated that ADM had strong
tumorigenicity, with its overexpression promoting cell growth,
migration and invasion. These results were in agreement with those
of previous studies (8,20). The two main types of primary liver
cancer are HCC and ICC. Although ADM may promote metastasis in both
ICC and HCC, the mechanisms appear to differ, possibly because of
the different origins of the two tumors. ICC results from the
malignant transformation of cholangiocytes. Gene expression
profiles analyzed by microarray identified ADM as a
metastasis-associated gene. Previous IHC analysis showed that HCC
samples with intra-hepatic metastasis expressed strong ADM
immunoreactivity in the cytoplasm of tumor cells (21). ADM signaling has been reported to be
hypoxia-inducible and functionally active in HCCs (20). In the present study, morphological
changes in ICC cells suggest a link between the biological function
of ADM and EMT induction. As anticipated, mesenchymal markers were
significantly upregulated in stable ADM transfectants, whereas
epithelial markers were significantly downregulated. In addition,
ADM silencing was associated with increased expression of
epithelial markers and decreased levels of mesenchymal markers.
ZEBl is the most important transcription factor in the regulation
of EMT in epithelial cells (22,23).
The present study provides the first evidence demonstrating that
ADM induces EMT through ZEB1.
Our study had some limitations. First, although
animal models offer an opportunity to bridge the gap between in
vitro findings and clinical applicability, such animal
experiments were not performed in the present study because of a
lack of time and experimental conditions. Second, we focused mainly
on patients with resectable ICC at a single institution, and
further multicenter studies are needed to validate the
findings.
In conclusion, overexpression of ADM in human ICC
cells led to increased growth, invasion and metastasis in
vitro. High ADM levels in clinical ICC specimens correlated
with poor prognosis. These findings suggest that ADM should be
evaluated as a potential novel therapeutic target in ICC with the
aim of improving the currently poor outcome of this disease.
Acknowledgments
This study was supported by the Science and
Technology Department of Henan Province Science Projects, China
(grant no. 132300410004).
References
|
1
|
Patel T: Increasing incidence and
mortality of primary intra-hepatic cholangiocarcinoma in the United
States. Hepatology. 33:1353–1357. 2001. View Article : Google Scholar : PubMed/NCBI
|
|
2
|
Razumilava N and Gores GJ:
Cholangiocarcinoma. Lancet. 383:2168–2179. 2014. View Article : Google Scholar : PubMed/NCBI
|
|
3
|
Rizvi S and Gores GJ: Pathogenesis,
diagnosis, and management of cholangiocarcinoma. Gastroenterology.
145:1215–1229. 2013. View Article : Google Scholar : PubMed/NCBI
|
|
4
|
Shaib Y and El-Serag HB: The epidemiology
of cholangiocar-cinoma. Semin Liver Dis. 24:115–125. 2004.
View Article : Google Scholar : PubMed/NCBI
|
|
5
|
Pascher A, Jonas S and Neuhaus P:
Intrahepatic cholangiocar-cinoma: Indication for transplantation. J
Hepatobiliary Pancreat Surg. 10:282–287. 2003. View Article : Google Scholar
|
|
6
|
Kitamura K, Kangawa K, Kawamoto M, Ichiki
Y, Nakamura S, Matsuo H and Eto T: Adrenomedullin: A novel
hypotensive peptide isolated from human pheochromocytoma. Biochem
Biophys Res Commun. 192:553–560. 1993. View Article : Google Scholar : PubMed/NCBI
|
|
7
|
Martínez A, Vos M, Guédez L, Kaur G, Chen
Z, Garayoa M, Pío R, Moody T, Stetler-Stevenson WG, Kleinman HK, et
al: The effects of adrenomedullin overexpression in breast tumor
cells. J Natl Cancer Inst. 94:1226–1237. 2002. View Article : Google Scholar : PubMed/NCBI
|
|
8
|
Ramachandran V, Arumugam T, Hwang RF,
Greenson JK, Simeone DM and Logsdon CD: Adrenomedullin is expressed
in pancreatic cancer and stimulates cell proliferation and invasion
in an autocrine manner via the adrenomedullin receptor, ADMR.
Cancer Res. 67:2666–2675. 2007. View Article : Google Scholar : PubMed/NCBI
|
|
9
|
Berenguer C, Boudouresque F, Dussert C,
Daniel L, Muracciole X, Grino M, Rossi D, Mabrouk K,
Figarella-Branger D, Martin PM, et al: Adrenomedullin, an
autocrine/paracrine factor induced by androgen withdrawal,
stimulates ‘neuroendocrine phenotype’ in LNCaP prostate tumor
cells. Oncogene. 27:506–518. 2008. View Article : Google Scholar
|
|
10
|
Zhu HT, Dong QZ, Wang G, Zhou HJ, Ren N,
Jia HL, Ye QH and Qin LX: Identification of suitable reference
genes for qRT-PCR analysis of circulating microRNAs in hepatitis B
virus-infected patients. Mol Biotechnol. 50:49–56. 2012. View Article : Google Scholar
|
|
11
|
Schmittgen TD and Livak KJ: Analyzing
real-time PCR data by the comparative C(T) method. Nat Protoc.
3:1101–1108. 2008. View Article : Google Scholar : PubMed/NCBI
|
|
12
|
Simon R, Mirlacher M and Sauter G: Tissue
microarrays. Biotechniques. 36:98–105. 2004.PubMed/NCBI
|
|
13
|
Zhou H, Huang H, Shi J, Zhao Y, Dong Q,
Jia H, Liu Y, Ye Q, Sun H, Zhu X, et al: Prognostic value of
interleukin 2 and interleukin 15 in peritumoral hepatic tissues for
patients with hepatitis B-related hepatocellular carcinoma after
curative resection. Gut. 59:1699–1708. 2010. View Article : Google Scholar : PubMed/NCBI
|
|
14
|
Aggarwal G, Ramachandran V, Javeed N,
Arumugam T, Dutta S, Klee GG, Klee EW, Smyrk TC, Bamlet W, Han JJ,
et al: Adrenomedullin is up-regulated in patients with pancreatic
cancer and causes insulin resistance in β scells and mice.
Gastroenterology. 143:1510–1517. 2012. View Article : Google Scholar
|
|
15
|
Chen P, Huang Y, Bong R, Ding Y, Song N,
Wang X, Song X and Luo Y: Tumor-associated macrophages promote
angiogenesis and melanoma growth via adrenomedullin in a paracrine
and autocrine manner. Clin Cancer Res. 17:7230–7239. 2011.
View Article : Google Scholar : PubMed/NCBI
|
|
16
|
Rhim AD, Mirek ET, Aiello NM, Maitra A,
Bailey JM, McAllister F, Reichert M, Beatty GL, Rustgi AK,
Vonderheide RH, et al: EMT and dissemination precede pancreatic
tumor formation. Cell. 148:349–361. 2012. View Article : Google Scholar : PubMed/NCBI
|
|
17
|
Ding W, You H, Dang H, LeBlanc F, Galicia
V, Lu SC, Stiles B and Rountree CB: Epithelial-to-mesenchymal
transition of murine liver tumor cells promotes invasion.
Hepatology. 52:945–953. 2010. View Article : Google Scholar : PubMed/NCBI
|
|
18
|
El Khatib M, Kalnytska A, Palagani V,
Kossatz U, Manns MP, Malek NP, Wilkens L and Plentz RR: Inhibition
of hedgehog signaling attenuates carcinogenesis in vitro and
increases necrosis of cholangiocellular carcinoma. Hepatology.
57:1035–1045. 2013. View Article : Google Scholar
|
|
19
|
Oishi N, Kumar MR, Roessler S, Ji J,
Forgues M, Budhu A, Zhao X, Andersen JB, Ye QH, Jia HL, et al:
Transcriptomic profiling reveals hepatic stem-like gene signatures
and interplay of miR-200c and epithelial-mesenchymal transition in
intra-hepatic cholangiocarcinoma. Hepatology. 56:1792–1803. 2012.
View Article : Google Scholar : PubMed/NCBI
|
|
20
|
Park SC, Yoon JH, Lee JH, Yu SJ, Myung SJ,
Kim W, Gwak GY, Lee SH, Lee SM, Jang JJ, et al: Hypoxia-inducible
adreno-medullin accelerates hepatocellular carcinoma cell growth.
Cancer Lett. 271:314–322. 2008. View Article : Google Scholar : PubMed/NCBI
|
|
21
|
Nakata T, Seki N, Miwa S, Kobayashi A,
Soeda J, Nimura Y, Kawasaki S and Miyagawa S: Identification of
genes associated with multiple nodules in hepatocellular carcinoma
using cDNA microarray: Multicentric occurrence or intrahepatic
metastasis? Hepatogastroenterology. 55:865–872. 2008.PubMed/NCBI
|
|
22
|
Sánchez-Tilló E, Siles L, de Barrios O,
Cuatrecasas M, Vaquero EC, Castells A and Postigo A: Expanding
roles of ZEB factors in tumorigenesis and tumor progression. Am J
Cancer Res. 1:897–912. 2011.PubMed/NCBI
|
|
23
|
Joseph JV, Conroy S, Tomar T,
Eggens-Meijer E, Bhat K, Copray S, Walenkamp AM, Boddeke E,
Balasubramanyian V, Wagemakers M, et al: TGF-β is an inducer of
ZEB1-dependent mesenchymal transdifferentiation in glioblastoma
that is associated with tumor invasion. Cell Death Dis.
5:e14432014. View Article : Google Scholar
|